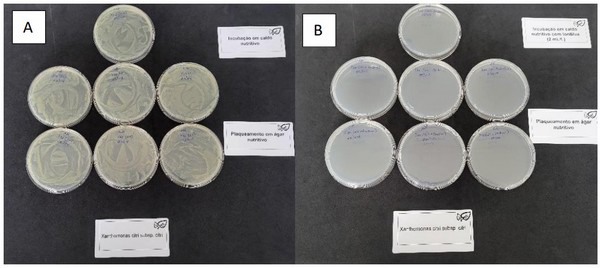

Xanthomonas citri, the bacterium that causes citrus canker, is causing serious trouble to the Brazilian Tahiti lime export sector, one of the major players in the international trade of this citrus fruit. Jorge Plaza Herrera, a producer of sour lime in Brazil for the last four years, talked to FreshPlaza about the rapid increase in the number of detections of fruit affected by the disease in the European Union, and recalled that it is subject to quarantine measures that can be decisive for its international marketing and threaten the continuity of fruit shipments.

"In recent months, there has been an increase in the number of Xanthomonas citri detections in limes from Brazil. The concern is such that we fear that the European Union could ban their import, which would be a disaster, since Europe is currently their most important market. That is why, eleven months ago, I started some private research aimed at finding out ways to efficiently tackle the Xanthomonas citri bacterium in partnership with a group of Spanish professionals with more than 30 years of experience in the fields of nutrition, crop protection and plant physiology. And we have come up with an effective solution: the latest generation of ionic copper."

"Conventional copper, while also bactericidal, does not eliminate the bacterium once it has already been inoculated in the leaf"
The disease thrives in high humidity combined with warm weather conditions. It can be spread by wind, rain or splashing water, and can be transmitted mechanically through the use of contaminated tools.

"Currently, to combat Xanthomonas citri, growers in most cases resort to the foliar application of conventional copper. According to our studies, trials and laboratory tests, conventional copper, while also bactericidal, does not eliminate the bacterium once it has already been inoculated in the leaf. This is due to the fact that conventional copper particles have a size of between 800 and 8,000 nanometers. When used via foliar application, the particles remain on the leaf in the form of small crystals, which cause burns on the leaf and the fruit. It protects a very limited area of the leaf (only where the crystal falls), leaving spaces between the copper crystals and consequently leaving them unprotected from the bacteria, which can continue spreading. We must also keep in mind that, after a copper application, the treatment will be washed away if it rains, leaving the plant completely unprotected."
"Growers spend a lot in copper applications, because they are highly concerned with Xanthomonas citri, but this is not really the most effective solution to the problem."
"Besides, a European program is going to further limit the amounts of copper metal allowed to be used in agriculture per unit area. Europe was given an extension that ends in 2026, limiting applications to an annual amount of 4 kg/ha of Cu2+, so the use of products with high copper concentrations is going to be severely restricted."
"In September it could already be available to be marketed throughout Brazil"
"After several live and laboratory trials with different tools available on the market worldwide, we have discovered a more advanced copper-sulfur formulation that uses nanometer technology to harness the power of copper ions, which we consider a next-generation copper. We've achieved some amazing results."

"Ionic copper is absorbed through cavities and connectors in every part of the plant, roots and leaves. It is able to penetrate bacteria and fungi by electrostatic interaction. Once inside the cell, Cu ions deactivate the enzyme responsible for respiration in the membrane, which is followed by DNA replication; production (DNA+plasmids) and gene transfer stops at the affected places, thereby preventing the spread of the infection."
"In live trials conducted in different plantations located in the São Paulo region, two foliar applications were carried out in a 7 day interval. The results were promising, with 100% bacterium inhibition. Although the results in terms of its curative effect were very positive, we need to validate and document them through a Brazilian laboratory that will accredit the method's technical efficiency."
"Trials are currently being carried out by a certified laboratory in Porto Alegre, Brazil. In the first in vitro trial, the result has been surprising, with the conclusion that ionic copper inhibits 100% of the growth of the bacteria, which corroborates that it is a promising formula to control citrus canker. Further live tests are being conducted by the laboratory to prove its efficacy for use as a curative and definitive treatment. We will have definitive results by the end of July."
"Ionic copper, moreover, can also be used in organic farming."
 For more information:
For more information:
Jorge Plaza
Europa Agropecuaria
Tel.: +55 41 99895 9668
jorge.plaza@europaagropecuaria.com
www.europaagropecuaria.com
